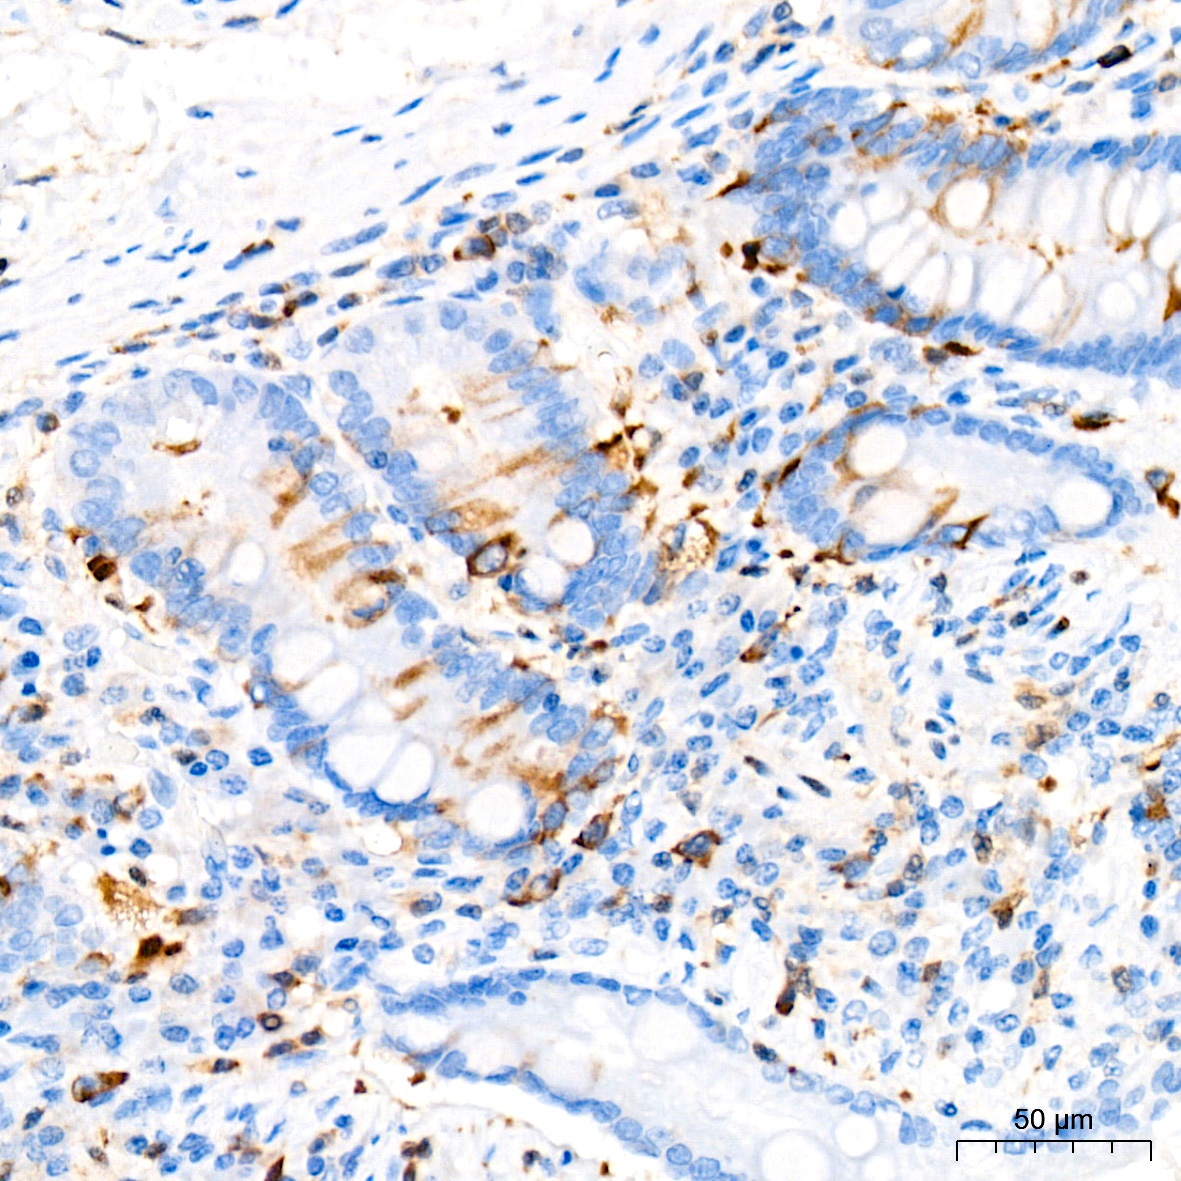
Product Image

Description
TACC3 Monoclonal Antibody (CAB19617)
The TACC3 Monoclonal Antibody (CAB19617) is a high-quality antibody developed for reliable detection and analysis of target proteins. This antibody is produced in rabbits and has been validated for use in Western blot applications, allowing for the detection and analysis of TACC3 in various cell types.TACC3 plays a crucial role in ensuring proper cell division and has been linked to cancer development and progression.
This antibody is validated for use in WB, IHC-P, IF/ICC, ELISA applications and has demonstrated reactivity against Human, Mouse, Rat samples.
| Product Name: | TACC3 Monoclonal Antibody |
| SKU: | CAB19617 |
| Size: | 20μL, 100μL |
| Reactivity: | Human, Mouse, Rat |
| Clone Number: | ARC2195 |
| Conjugate: | Unconjugated |
| Immunogen: | Synthetic peptide. This information is considered to be commercially sensitive. | ||||||||
| Sequence: | MSLQ VLND KNVS NEKN TENC DFLF SPPE VTGR SSVL RVSQ KENV PPKN LAKA MKVT FQTP LRDP QTHR ILSP SMAS KLEA PFTQ DDTL GLEN SHPV WTQK | ||||||||
| Tested Applications: | WB IHC-P IF/ICC ELISA | ||||||||
| Recommended Dilution: |
| ||||||||
| Synonyms: | ERIC1, Tacc4, ERIC-1, maskin, TACC3 |
| Positive Sample: | 293T |
| Cellular Localization: | Cytoplasm, Cytosol, Mitotic Spindle, Spindle Pole. |
| Calculated MW: | 90kDa |
| Observed MW: | 140kDa |
TACC3, also known as ERIC 1, belongs to the TACC family. TACC family members TACC1, TACC2, and TACC3 map very closely to the corresponding FGFR1, FGFR2, FGFR3 genes on chromosomes 8, 10, and 4. Subsequently, since they are phylogenetically related, it is proposed that TACC and FGFR have similar roles in cell growth and differentiation. It plays a role in the microtubule-dependent coupling of the nucleus and the centrosome and involved in the processes that regulate centrosome-mediated interkinetic nuclear migration (INM) of neural progenitors.
| Purification Method | Affinity purification |
| Gene ID | 10460 |
| Buffer Information | Store at -20℃. Avoid freeze / thaw cycles. Buffer: PBS containing 50% glycerol and 0.05% BSA, preserved with proclin300 or sodium azide, pH 7.3. |